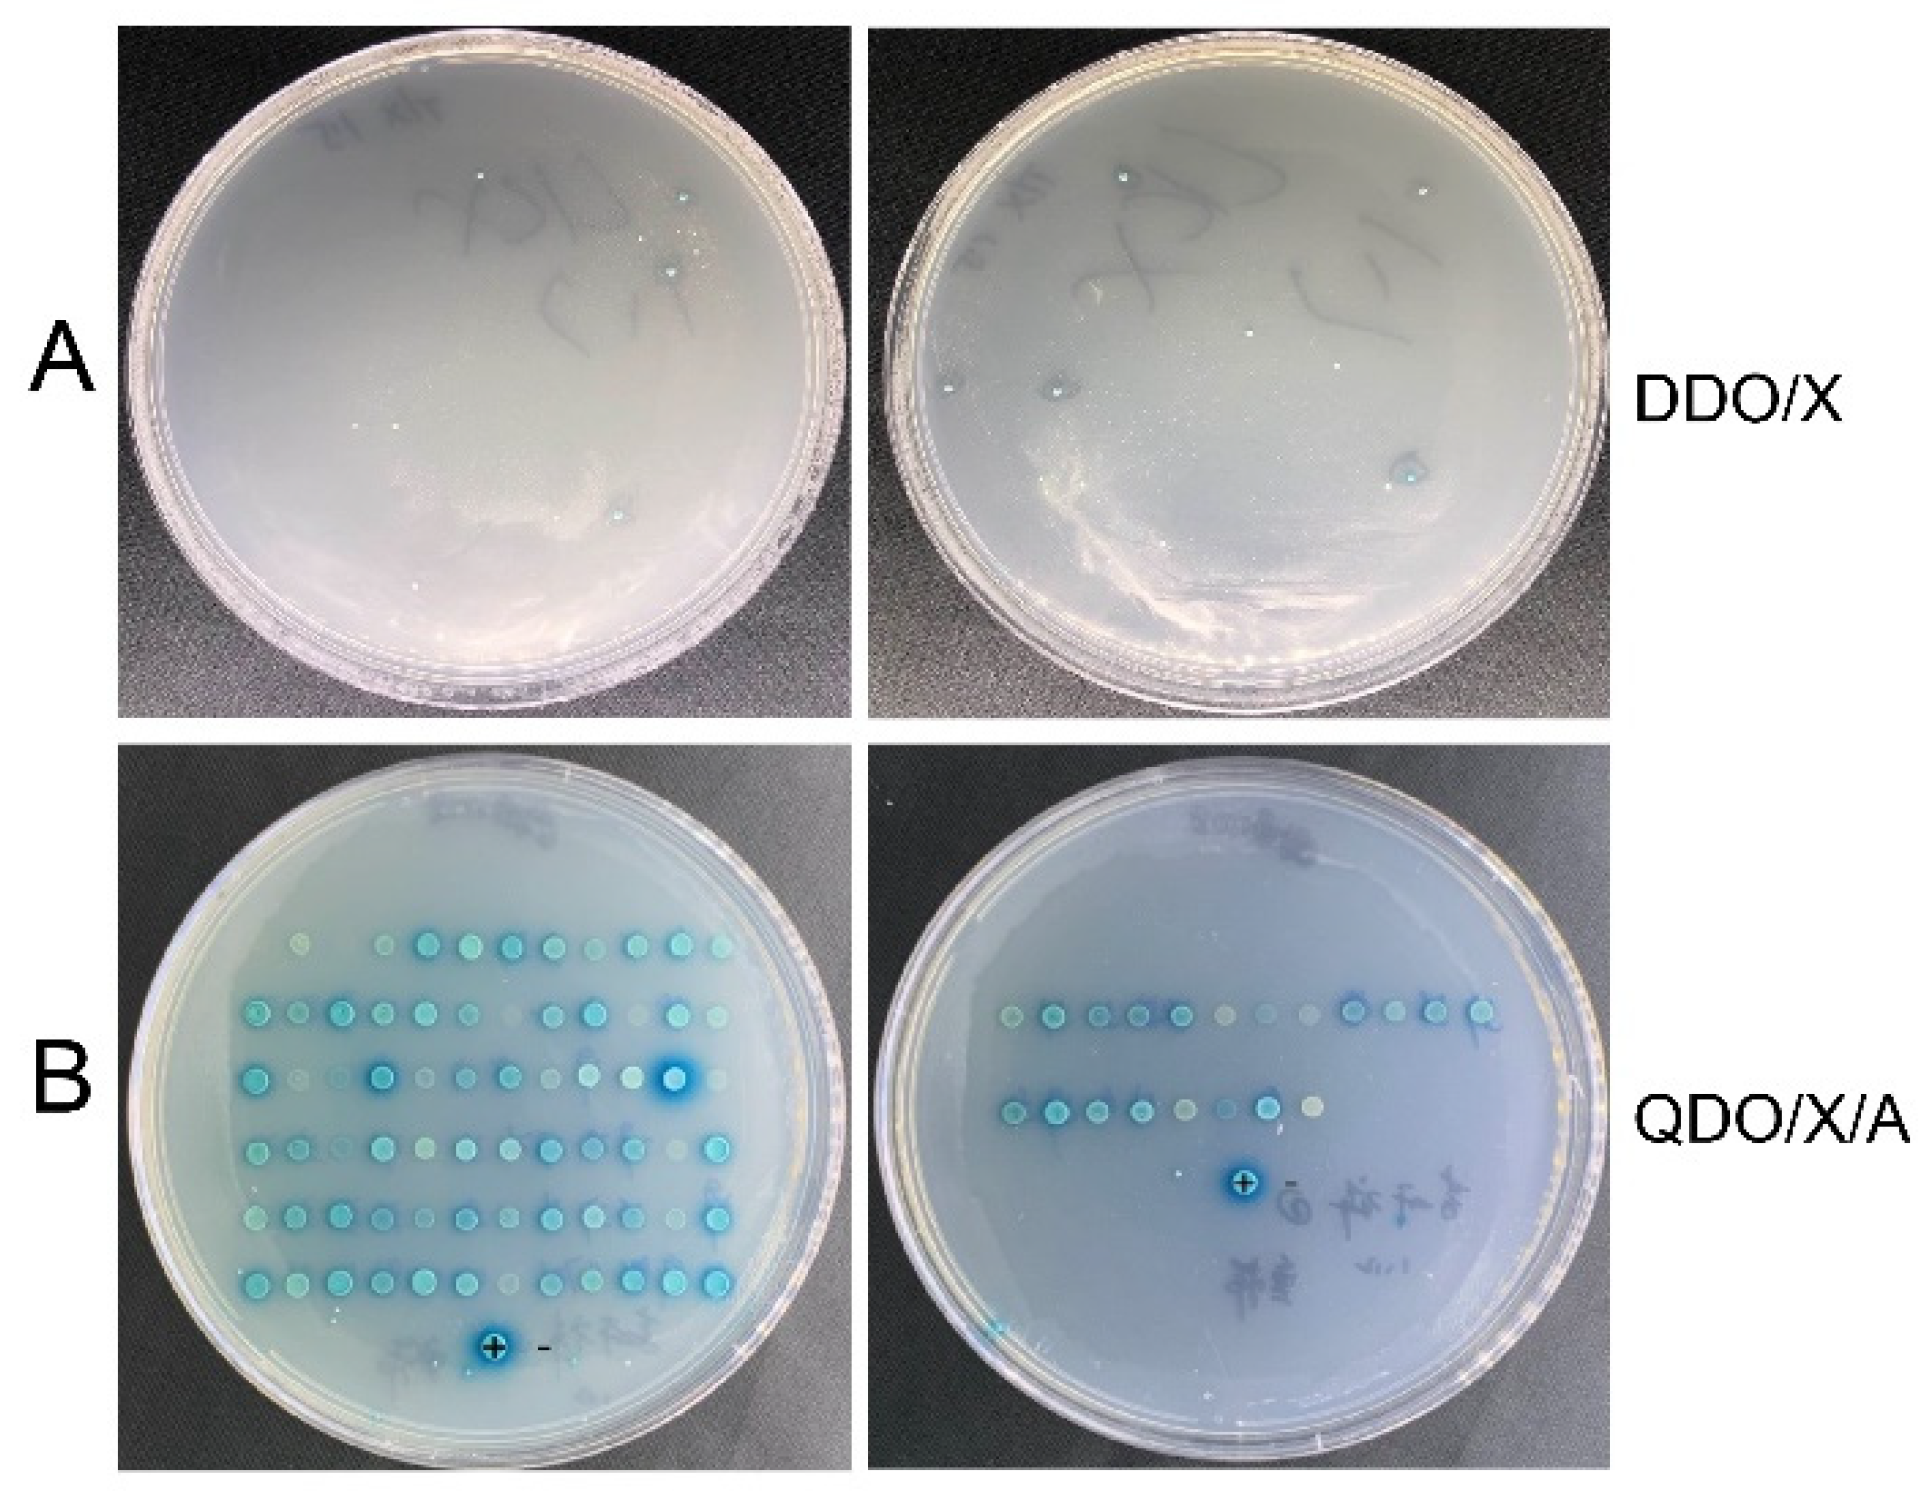

Construction of Shoot Apical Meristem cDNA Yeast Library of Brassica napus L. and Screening of Proteins That Interact with the Inflorescence Regulatory Factors BnTFL1s
Abstract
1. Introduction
2. Materials and Methods
2.1. Plant Materials and Growth Conditions
2.2. RNA Extraction and cDNA Library Construction
2.3. Library Capacity and Insert Length Identification
2.4. Yeast Secondary Library Construction
2.5. Construction of theY2H Bait Vector pGBKT7-BnTFL1s
2.6. Detection of Bait Vector Toxicity and Self-Activation
2.7. Screening for BnTFL1s-Interacting Proteins
2.8. Identification and Validation of Candidate Interacting Proteins
3. Results
3.1. Total RNA Extraction, mRNA Purification, and Double-Stranded cDNA Synthesis
3.2. Construction and Identification of the B. napus SAM Y2H Library
3.3. Construction of Bait Vector pGBKT7-BnTFL1s
3.4. Toxicity and Self-Activation Activity of pGBKT7-BnTFL1s
3.5. Screening of BnTFL1s-Interacting Proteins
3.6. One-to-One Verification of Candidate Proteins Interacting with pGBKT7-BnTFL1s
3.7. Analysis of TFL1 and 14-3-3 Interaction in B. rapa L. and B. oleracea L.
4. Discussion
5. Conclusions
Supplementary Materials
Author Contributions
Funding
Institutional Review Board Statement
Informed Consent Statement
Data Availability Statement
Acknowledgments
Conflicts of Interest
References
- Li, K.; Yao, Y.; Xiao, L.; Zhao, Z.; Guo, S.; Fu, Z.; Du, D. Fine mapping of the Brassica napus Bnsdt1 gene associated with determinate growth habit. Theor. Appl. Genet. 2017, 131, 193–208. [Google Scholar] [CrossRef]
- Li, K.; Chen, C.; Jia, Y.; Du, D. Effect of Determinate Inflorescence on Agronomic Traits of Brassica napus. Acta Agric. Boreali-Occident. Sin. 2021, 30, 689–697. [Google Scholar]
- Li, K.; Xu, L.; Jia, Y.; Chen, C.; Yao, Y.; Liu, H.; Du, D. A novel locus (Bnsdt2) in a TFL1 homologue sustaining determinate growth in Brassica napus. BMC Plant Biol. 2021, 21, 568. [Google Scholar] [CrossRef] [PubMed]
- Jia, Y.; Li, K.; Liu, H.; Zan, L.; Du, D. Characterization of the BnA10.tfl1 Gene Controls Determinate Inflorescence Trait in Brassica napus L. Agronomy 2019, 9, 722. [Google Scholar] [CrossRef]
- Zhao, X.; Zan, L.; He, N.; Liu, H.; Xing, X.; Du, D.; Tang, G.; Li, K. BnaC09. tfl1 controls determinate inflorescence trait in Brassica napus. Mol. Breed. 2024, 44, 68. [Google Scholar] [CrossRef] [PubMed]
- Hanano, S.; Goto, K. ArabidopsisTERMINAL FLOWER1 Is Involved in the Regulation of Flowering Time and Inflorescence Development through Transcriptional Repression. Plant Cell 2011, 23, 3172–3184. [Google Scholar] [CrossRef] [PubMed]
- Kaneko-Suzuki, M.; Kurihara-Ishikawa, R.; Okushita-Terakawa, C.; Kojima, C.; Nagano-Fujiwara, M.; Ohki, I.; Tsuji, H.; Shimamoto, K.; Taoka, K.-I. TFL1-like proteins in rice antagonize rice FT-like protein in inflorescence development by competition for complex formation with 14-3-3 and FD. Plant Cell Physiol. 2018, 59, 458–468. [Google Scholar] [CrossRef]
- Wen, C.; Zhao, W.; Liu, W.; Yang, L.; Zhang, X. CsTFL1 inhibits determinate growth and terminal flower formation through interaction with CsNOT2a in cucumber (Cucumis sativus L.). Development 2019, 146, dev.180166. [Google Scholar] [CrossRef]
- Asadi Khanouki, M.; Rezanejad, F.; Millar, A.A. Sequence and functional analysis of a TERMINAL FLOWER 1 homolog from Brassica juncea: A putative biotechnological tool for flowering time adjustment. GM Crops Food 2020, 11, 79–92. [Google Scholar] [CrossRef] [PubMed]
- Guo, Y.; Hans, H.; Christian, J.; Molina, C. Mutations in single FT-and TFL1-paralogs of rapeseed (Brassica napus L.) and their impact on flowering time and yield components. Front. Plant Sci. 2014, 5, 282. [Google Scholar] [CrossRef] [PubMed]
- Sriboon, S.; Li, H.; Guo, C.; Senkhamwong, T.; Dai, C.; Liu, K. Knock-out of TERMINAL FLOWER 1 genes altered flowering time and plant architecture in Brassica napus. BMC Genet. 2020, 21, 52. [Google Scholar] [CrossRef] [PubMed]
- Zhu, Y.; Klasfeld, S.; Jeong, C.W.; Jin, R.; Goto, K.; Yamaguchi, N.; Wagner, D. TERMINAL FLOWER 1-FD complex target genes and competition with FLOWERING LOCUS T. Nat. Commun. 2020, 11, 5118. [Google Scholar] [CrossRef]
- Miller, J.; Stagljar, I. Using the yeast two-hybrid system to identify interacting proteins. Methods Mol. Biol. 2004, 261, 247–262. [Google Scholar]
- Stynen, B.; Tournu, H.; Tavernier, J.; Dijck, P.V. Diversity in Genetic In Vivo Methods for Protein-Protein Interaction Studies: From the Yeast Two-Hybrid System to the Mammalian Split-Luciferase System. Microbiol. Mol. Biol. Rev. 2012, 76, 331–382. [Google Scholar] [CrossRef] [PubMed]
- Gao, J.-X.; Jing, J.; Yu, C.-J.; Chen, J. Construction of a High-Quality Yeast Two-Hybrid Library and Its Application in Identification of Interacting Proteins with Brn1 in Curvularia lunata. Plant Pathol. J. 2015, 31, 108–114. [Google Scholar] [CrossRef] [PubMed]
- Zhang, L.; Zhou, H.; Wei, F.; Cheng, Z.; Yan, A.; Wang, D. Construction of yeast two-hybrid cDNA libraries for wheat near-isogenic line TcLr19 under the stress of Puccinia recondita and its preliminary appreciation. Front. Agric. China 2011, 5, 450–455. [Google Scholar] [CrossRef]
- He, Y.; Wu, L.; Liu, X.; Zhang, X.; Ma, H. Yeast two-hybrid screening for proteins that interact with PFT in wheat. Sci. Rep. 2019, 9, 15521. [Google Scholar] [CrossRef] [PubMed]
- Xu, Y.; Zhou, J.; Liu, Q.; Li, K.; Zhou, Y. Construction and characterization of a high-quality cDNA library of Cymbidium faberi suitable for yeast one- and two-hybrid assays. BMC Biotechnol. 2020, 20, 4. [Google Scholar] [CrossRef] [PubMed]
- Han, X.F.; Luo, J.; Wu, N.; Matand, K.; Yang, B.J.; Wu, H.J.; Zhang, L.J.; Wang, H.B. Construction and Characterization of a Goat Mammary Gland cDNA Library. Mol. Biotechnol. 2007, 38, 187–193. [Google Scholar] [CrossRef] [PubMed]
- Zhao, W.J.; Zhang, H.; Bo, X.; Li, Y.; Fu, X. Generation and analysis of expressed sequence tags from a cDNA library of Moniezia expansa. Mol. Biochem. Parasitol. 2009, 164, 80–85. [Google Scholar] [CrossRef] [PubMed]
- Taoka, K.-i.; Ohki, I.; Tsuji, H.; Furuita, K.; Hayashi, K.; Yanase, T.; Yamaguchi, M.; Nakashima, C.; Purwestri, Y.A.; Tamaki, S.; et al. 14-3-3 proteins act as intracellular receptors for rice Hd3a florigen. Nature 2011, 476, 332–335. [Google Scholar] [CrossRef] [PubMed]
- Zuo, X.; Wang, S.; Xiang, W.; Yang, H.; Tahir, M.M.; Zheng, S.; An, N.; Han, M.; Zhao, C.; Zhang, D. Genome-wide identification of the 14–3-3 gene family and its participation in floral transition by interacting with TFL1/FT in apple. BMC Genom. 2021, 22, 41. [Google Scholar] [CrossRef] [PubMed]
- Collani, S.; Neumann, M.; Yant, L.; Schmid, M. FT modulates genome-wide DNA-binding of the bZIP transcription factor FD. Plant Physiol. 2019, 180, 367–380. [Google Scholar] [CrossRef] [PubMed]
- Zhang, P.; Liu, H.; Mysore, K.S.; Wen, J.; Meng, Y.; Lin, H.; Niu, L. MtFDa is essential for flowering control and inflorescence development in Medicago truncatula. J. Plant Physiol. 2021, 260, 153412. [Google Scholar] [CrossRef]
- Yao, W.J.; Wang, Y.P.; Peng, J.; Yin, P.P.; Gao, H.; Xu, L.; Laux, T.; Zhang, X.S.; Su, Y.H. The RPT2a–MET1 axis regulates TERMINAL FLOWER1 to control inflorescence meristem indeterminacy in Arabidopsis. Plant Cell 2024, 36, 1718–1735. [Google Scholar] [CrossRef] [PubMed]
- Sun, X.; Wang, E.; Yu, L.; Liu, S.; Liu, T.; Qin, J.; Jiang, P.; He, S.; Cai, X.; Jing, S. TCP transcription factor StAST1 represses potato tuberization by regulating tuberigen complex activity. Plant Physiol. 2024, 195, 1347–1364. [Google Scholar] [CrossRef] [PubMed]
- Yang, Y.; Nicolas, M.; Zhang, J.; Yu, H.; Guo, D.; Yuan, R.; Zhang, T.; Yang, J.; Cubas, P.; Qin, G. The TIE1 transcriptional repressor controls shoot branching by directly repressing BRANCHED1 in Arabidopsis. PLoS Genet. 2018, 14, e1007296. [Google Scholar] [CrossRef]
- Yu, X.; Liu, H.; Sang, N.; Li, Y.; Zhang, T.; Sun, J.; Huang, X. Identification of cotton MOTHER OF FT AND TFL1 homologs, GhMFT1 and GhMFT2, involved in seed germination. PLoS ONE 2019, 14, e0215771. [Google Scholar] [CrossRef] [PubMed]
- Sussmilch, F.C.; Berbel, A.; Hecht, V.; Vander Schoor, J.K.; Ferrándiz, C.; Madueño, F.; Weller, J.L. Pea VEGETATIVE2 is an FD homolog that is essential for flowering and compound inflorescence development. Plant Cell 2015, 27, 1046–1060. [Google Scholar] [CrossRef] [PubMed]
- Skirpan, A.; Wu, X.; McSteen, P. Genetic and physical interaction suggest that BARREN STALK1 is a target of BARREN INFLORESCENCE2 in maize inflorescence development. Plant J. 2008, 55, 787–797. [Google Scholar] [CrossRef]
- Zhang, X.; Campbell, R.; Ducreux, L.J.; Morris, J.; Hedley, P.E.; Mellado-Ortega, E.; Roberts, A.G.; Stephens, J.; Bryan, G.J.; Torrance, L. TERMINAL FLOWER-1/CENTRORADIALIS inhibits tuberisation via protein interaction with the tuberigen activation complex. Plant J. 2020, 103, 2263–2278. [Google Scholar] [CrossRef] [PubMed]
- Wang, J.; Zhang, C.; Chen, Y.; Shao, Y.; Liao, M.; Hou, Q.; Zhang, W.; Zhu, Y.; Guo, Y.; Liu, Z. The BnTFL1–BnGF14nu–BnFD module regulates flower development and plant architecture in Brassica napus. Crop J. 2023, 11, 1696–1710. [Google Scholar] [CrossRef]
- Song, P.; Yang, Z.; Guo, C.; Han, R.; Wang, H.; Dong, J.; Kang, D.; Guo, Y.; Yang, S.; Li, J. 14-3-3 proteins regulate photomorphogenesis by facilitating light-induced degradation of PIF3. New Phytol. 2023, 237, 140–159. [Google Scholar] [CrossRef] [PubMed]
- Bai, M.-Y.; Zhang, L.-Y.; Gampala, S.S.; Zhu, S.-W.; Song, W.-Y.; Chong, K.; Wang, Z.-Y. Functions of OsBZR1 and 14-3-3 proteins in brassinosteroid signaling in rice. Proc. Natl. Acad. Sci. USA 2007, 104, 13839–13844. [Google Scholar] [CrossRef] [PubMed]
- Chen, Y.; Zhou, X.; Chang, S.; Chu, Z.; Wang, H.; Han, S.; Wang, Y. Calcium-dependent protein kinase 21 phosphorylates 14-3-3 proteins in response to ABA signaling and salt stress in rice. Biochem. Biophys. Res. Commun. 2017, 493, 1450–1456. [Google Scholar] [CrossRef] [PubMed]
- Sun, J.; Zhang, G.; Cui, Z.; Kong, X.; Yu, X.; Gui, R.; Han, Y.; Li, Z.; Lang, H.; Hua, Y. Regain flood adaptation in rice through a 14-3-3 protein OsGF14h. Nat. Commun. 2022, 13, 5664. [Google Scholar] [CrossRef]
- Wang, N.; Shi, Y.; Jiang, Q.; Li, H.; Fan, W.; Feng, Y.; Li, L.; Liu, B.; Lin, F.; Jing, W. A 14-3-3 protein positively regulates rice salt tolerance by stabilizing phospholipase C1. Plant Cell Environ. 2023, 46, 1232–1248. [Google Scholar] [CrossRef] [PubMed]
- Deb, S.; Gupta, M.K.; Patel, H.K.; Sonti, R.V. Xanthomonas oryzae pv. oryzae XopQ protein suppresses rice immune responses through interaction with two 14-3-3 proteins but its phospho-null mutant induces rice immune responses and interacts with another 14-3-3 protein. Mol. Plant Pathol. 2019, 20, 976–989. [Google Scholar] [CrossRef]
- Shao, W.; Chen, W.; Zhu, X.; Zhou, X.; Jin, Y.; Zhan, C.; Liu, G.; Liu, X.; Ma, D.; Qiao, Y. Genome-wide identification and characterization of wheat 14-3-3 genes unravels the role of TaGRF6-A in salt stress tolerance by binding MYB transcription factor. Int. J. Mol. Sci. 2021, 22, 1904. [Google Scholar] [CrossRef]

| AD Number | Putative Function | Gene Name |
|---|---|---|
| 1, 3, 5, 29, 36, 38, 39 | 14-3-3-like protein GF14 lambda [B. rapa] | XP_009125300.1 |
| 2 | mitochondrial outer membrane protein porin 3 [B. napus] | XP_013662361.1 |
| 6 | 14-3-3-like protein GF14 psi [B. napus] | XP_022552879.1 |
| 35 | ||
| 8 | unnamed protein product, partial [B. oleracea] | VDD64795.1 |
| 9 | protein phosphatase 2C 70 isoform X1 [B. rapa] | XP_009120903.1 |
| 10 | unnamed protein product, partial [B. oleracea] | VDD62767.1 |
| 13 | mitochondrial outer membrane protein porin 3-like [B. oleracea] | XP_013606965.1 |
| 19 | pentatricopeptide repeat-containing protein At2g17670 [B. napus] | XP_013693355.1 |
| 26 | mitochondrial outer membrane protein porin 1-like [B. oleracea] | XP_013637592.1 |
| 28 | hypothetical protein F2Q69_00054638, partial [B. cretica] | KAF3485538.1 |
| 31 | protein LHCP TRANSLOCATION DEFECT-like [B. oleracea] | XP_013638801.1 |
| 33 | heat stress transcription factor A-4a [B. rapa] | XP_009136968.1 |
| 37 | glyceradehyde-3-phosphate dehydrogenase, partial [B. rapa] | BAJ10476.1 |
| AD | Gene Bank | (TDO/X) | (QDO/X/A) | Arabidopsis Homologous |
|---|---|---|---|---|
| 1 | BnaC09G0088500ZS/BnaA09G0091600ZS | growth | no growth | 14-3-3-like protein GF14 kappa GRF8 |
| 8 | BnaC06G0440000ZS/BnaA07G0374100ZS | growth | blue | 14-3-3-like protein GF14 omega GRF2 |
| 10 | BnaA07G0235600ZS/BnaC06G0256100ZS | growth | blue | 14-3-3-like protein GF14 omega GRF2 |
| 28 | BnaC07G0182400ZS/BnaA07G0123900ZS | growth | no growth | 14-3-3-like protein GF14 epsilon GRF10 |
| 2 | XP_013662361.1 | growth | blue |
Disclaimer/Publisher’s Note: The statements, opinions and data contained in all publications are solely those of the individual author(s) and contributor(s) and not of MDPI and/or the editor(s). MDPI and/or the editor(s) disclaim responsibility for any injury to people or property resulting from any ideas, methods, instructions or products referred to in the content. |
© 2024 by the authors. Licensee MDPI, Basel, Switzerland. This article is an open access article distributed under the terms and conditions of the Creative Commons Attribution (CC BY) license (https://creativecommons.org/licenses/by/4.0/).
Share and Cite
Zan, L.; Liu, H.; Zhao, X.; Du, D.; Li, K. Construction of Shoot Apical Meristem cDNA Yeast Library of Brassica napus L. and Screening of Proteins That Interact with the Inflorescence Regulatory Factors BnTFL1s. Curr. Issues Mol. Biol. 2025, 47, 15. https://doi.org/10.3390/cimb47010015
Zan L, Liu H, Zhao X, Du D, Li K. Construction of Shoot Apical Meristem cDNA Yeast Library of Brassica napus L. and Screening of Proteins That Interact with the Inflorescence Regulatory Factors BnTFL1s. Current Issues in Molecular Biology. 2025; 47(1):15. https://doi.org/10.3390/cimb47010015
Chicago/Turabian StyleZan, Lingxiong, Haidong Liu, Xutao Zhao, Dezhi Du, and Kaixiang Li. 2025. "Construction of Shoot Apical Meristem cDNA Yeast Library of Brassica napus L. and Screening of Proteins That Interact with the Inflorescence Regulatory Factors BnTFL1s" Current Issues in Molecular Biology 47, no. 1: 15. https://doi.org/10.3390/cimb47010015
APA StyleZan, L., Liu, H., Zhao, X., Du, D., & Li, K. (2025). Construction of Shoot Apical Meristem cDNA Yeast Library of Brassica napus L. and Screening of Proteins That Interact with the Inflorescence Regulatory Factors BnTFL1s. Current Issues in Molecular Biology, 47(1), 15. https://doi.org/10.3390/cimb47010015
